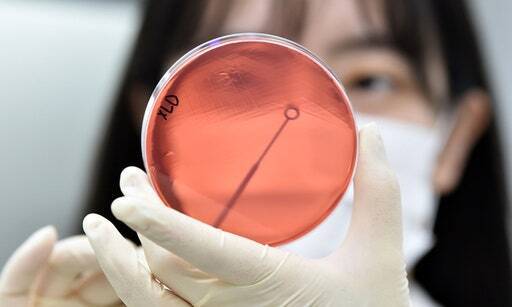
식중독균 배양분리작업 하는 모습. 뉴시스

“침수된 음식 절대 먹지 마세요”‥‘장마 끝, 폭염 시작’ 식중독 확산 경고
전체 맥락을 이해하기 위해서는 본문 보기를 권장합니다.
기록적인 폭우가 끝나자마자 낮 최고기온이 34도까지 오를 것으로 예보된 가운데 침수된 식재료 등 관리에 더욱 주의해야 한다.
22일 식품의약품안전처에 따르면 집중 호우로 하천 등이 범람하면서 가축의 분뇨 또는 퇴비 등이 주변에 유출될 경우 지하수나 채소를 오염시켜 식중독이 발생할 수 있다.
샐러드, 생채 무침 등 가열 조리하지 않는 채소를 섭취할 경우, 염소 소독액(100ppm)에서 5분 이상 담근 후 3회 이상 수돗물로 충분히 헹군 다음 조리한다.
이 글자크기로 변경됩니다.
(예시) 가장 빠른 뉴스가 있고 다양한 정보, 쌍방향 소통이 숨쉬는 다음뉴스를 만나보세요. 다음뉴스는 국내외 주요이슈와 실시간 속보, 문화생활 및 다양한 분야의 뉴스를 입체적으로 전달하고 있습니다.
식중독균 35℃서 2~3시간 만에 100배로 증가
기록적인 폭우가 끝나자마자 낮 최고기온이 34도까지 오를 것으로 예보된 가운데 침수된 식재료 등 관리에 더욱 주의해야 한다.

22일 식품의약품안전처에 따르면 집중 호우로 하천 등이 범람하면서 가축의 분뇨 또는 퇴비 등이 주변에 유출될 경우 지하수나 채소를 오염시켜 식중독이 발생할 수 있다.
또한 폭우가 끝난 직후에는 온도와 습도가 높아지면 식중독균이 증식하기 좋은 환경이 된다. 식중독균은 35℃에서 2~3시간 만에 100배로 증가하고, 4~7시간이면 1만 배로 증가하는 반면 10℃ 이하의 온도에서는 100배 증가하는 데 65~80시간이나 걸린다. 원재료 또한 오염되기 쉬우므로 채소류를 익히지 않고 섭취하는 경우 주의가 필요하다.
풍수해 감염병에는 ▲오염된 물이나 음식 섭취로 인한 수인성·식품 매개 감염병 ▲물웅덩이 등 모기 증식이 쉬운 환경으로 인한 모기 매개 감염병 ▲오염된 물 등에 직접 노출로 인한 접촉성 피부염, 렙토스피라증, 안과 감염병 등이 있다.
하천 등이 범람해 침수됐거나 침수가 의심되는 식품은 폐기한다. 샐러드, 생채 무침 등 가열 조리하지 않는 채소를 섭취할 경우, 염소 소독액(100ppm)에서 5분 이상 담근 후 3회 이상 수돗물로 충분히 헹군 다음 조리한다.
염소 소독액을 만드는 방법은 간단하다. 식품첨가물로 표기된 유효염소 4%짜리 염소 소독제를 약 400배 희석하면 된다. 소독제 0.1리터(종이컵 반 컵)에 물 40리터(종이컵 200컵 분량)을 넣어서 만들면 된다.
과일 수박, 참외, 복숭아 등은 과일·채소용 세척제를 이용해 과일 표면을 닦아내고 수돗물로 잘 헹궈서 섭취한다. 약수터 등의 지하수는 끓여서 마시고, 지하수를 식품용수로 사용하는 경우 살균소독장치가 정상 작동하는지 확인하고 사용하다.
곰팡이가 발생하기 쉬운 견과류, 땅콩은 밀봉해 가급적 냉장 또는 냉동 보관하고, 곡류, 두류 등 건조 농산물은 잘 밀봉하여 건조한 곳에 보관한다. 침수 등으로 정전 시에는 냉장·냉동을 최대한 유지하도록 냉장고 문을 자주 열지 말고, 정전이 길어져 식품의 변질이 의심되는 경우는 폐기한다.

조리한 음식은 2시간 이내에 먹는 것이 좋고, 보관할 때는 냉장·냉동해야 하며, 남은 음식이나 즉석식품을 섭취하기 전에는 충분한 온도에서 재가열한 후 섭취한다. 또 필요한 만큼만 조리해 먹는 것이 바람직하며 미생물의 증식을 최소화하기 위해서는 실온까지의 냉각시간과 냉장·냉각시간을 준수해야 한다.
황만기키본한의원 황만기 대표원장(한의학박사)은 “비위 기능이 약한 소음인들은, 여름철 식중독에 더욱 취약하고, 식중독 후유증도 훨씬 오래 지속되는 경향이 뚜렷하다”며 “특히 위암·대장암·식도암·췌장암 등과 같은 소화기암 환자들은 악액질상황 즉 만성적 식욕부진·급격한 체중 감소·심한 체력 감퇴·비자발적인 근육 소실·빈혈·소화불량이 소화기가 예민해지기 쉬운 여름철에 증상이 더 심해질 수 있다”고 설명했다.
이어 “폭염이 지속되는 여름철 소화기 건전성 회복을 위한 적극적인 체질개선이 필요하다”고 덧붙였다.
김경호 기자 stillcut@segye.com
Copyright © 세계일보. 무단전재 및 재배포 금지.
- “화장실 문까지 순금” 김준수, 300억 펜트하우스의 삶…천억원 대 자산 비결
- “박나래가 합의 거절…새 삶 살고 싶다” 선처 호소한 자택 절도범
- “투명인간 같았다” 김지연, 이혼 13년 만에 ‘강남 자가’ 일군 100억원 반전
- “화장지 반 칸 아껴 4200% 대박” 전원주, 지점장 뛰어나오게 만든 ‘3000원’의 힘
- “양수 터졌어요” 20대 신고…병원들 ‘거절’에 결국 구급차서 출산
- 조영구, 15kg와 맞바꾼 건강…“가정도 잃을 뻔한 60일의 지옥” [스타's 헬스]
- 3년간 전교 1등만 하던 여고생…새벽 1시, 교무실서 무슨일이 [사건 속으로]
- “배 아파서 잠이 안 와요”…60만원에 다 던진 개미들, 자고나니 ‘날벼락’
- 박세리·김승수 결혼설은 가짜, 재력은 ‘진짜’ [스타's 머니]
- 이제훈·손석구, 출연료는 거들 뿐…경영 수익만 ‘수십억’ [스타's 머니]